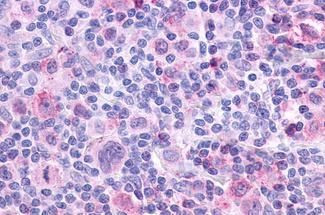
CHRM4 Antibody in Immunohistochemistry (Paraffin) (IHC (P))

Search
Invitrogen
CHRM4 Polyclonal Antibody
{{$productOrderCtrl.translations['antibody.pdp.commerceCard.promotion.promotions']}}
{{$productOrderCtrl.translations['antibody.pdp.commerceCard.promotion.viewpromo']}}
{{$productOrderCtrl.translations['antibody.pdp.commerceCard.promotion.promocode']}}: {{promo.promoCode}} {{promo.promoTitle}} {{promo.promoDescription}}. {{$productOrderCtrl.translations['antibody.pdp.commerceCard.promotion.learnmore']}}
产品信息
PA1-23544
宿主/亚型
分类
类型
抗原
偶联物
形式
浓度
规格
保存条件
运输条件
RRID
产品详细信息
PA1-23544 detects Muscarinic Acetylcholine Receptor M4 in Human samples.
靶标信息
Muscarinic acetylcholine receptor M4 is an Acetylcholine Receptor. Unlike muscarinic receptor M2, the M4 receptor is not involved in smooth muscle contraction. The clinical relevance of this receptor is unknown. However, mouse studies have linked it to adenylyl cyclase inhibition. Muscarinic acetylcholine receptor M4 has been reported to be expressed in many regions of the rat brain, particularly the striatum and hippocampus. ESTs have been isolated from human breast and eye libraries.
仅用于科研。不用于诊断过程。未经明确授权不得转售。